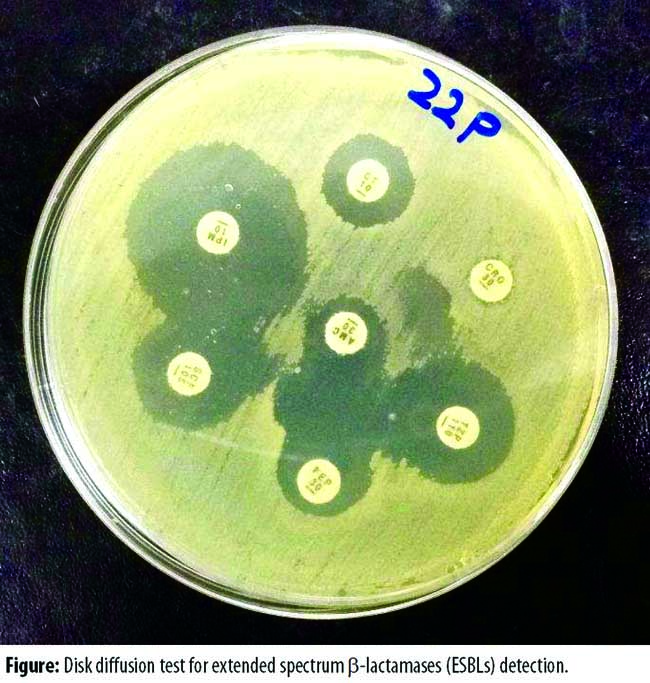

Bushra Jamil ( Department of Biosciences, Comsats Institute of Information Technology. Islamabad, Pakistan. )
Mohammad Tauseef Mukhtar Bokhari ( Al-Sayed Hospital (Pvt) Ltd. Rawalpindi. )
Azhar Saeed ( Department of Biosciences, Comsats Institute of Information Technology. Islamabad, Pakistan. )
Mohammad Zahid Mukhtar Bokhari ( Department of Biosciences, Comsats Institute of Information Technology. Islamabad, Pakistan. )
Zakir Hussain ( Department of Biosciences, Comsats Institute of Information Technology. Islamabad, Pakistan. )
Tayabba Khalid ( Al-Sayed Hospital (Pvt) Ltd. Rawalpindi. )
Habib Bukhari ( Department of Biosciences, Comsats Institute of Information Technology. Islamabad, Pakistan )
Muhammad Imran ( Department of Biosciences, Comsats Institute of Information Technology. Islamabad, Pakistan. )
Shahid Ahmad Abbasi ( Al-Sayed Hospital (Pvt) Ltd. Rawalpindi. )
June 2016, Volume 66, Issue 6
Original Article
Abstract
Objective: To determine the prevalence of bacteraemia in patients with chronic kidney disease, particularly those on dialysis and those who had had renal transplant, and to evaluate resistance among the isolated strains.
Method: The cross-sectional study was conducted at Kidney Centre, Al-Sayyed Hospital, Rawalpindi, Pakistan, from June to December 2014. Samples that displayed positive growth were separated from the rest. The isolates were then identified and screened for extended spectrum beta lactamases and metallo beta lactamases production and other resistance mechanisms by phenotypic method.
Results: Of the 1400 samples, only 46 samples (3.3%) displayed signal for positive growth. The prevalence of extended spectrum beta lactamase (ESBL) producing strains was recorded to be 37%.Carbapenem resistance was witnessed in 15% samples. Whereas, Methicillin-resistant staphylococcus aureus prevalence was detected to be 2%.
Conclusion: Resistance in gram-negative microbes was rising, while it was declining in gram-positive microbes.
Keywords: Bacteraemia, Chronic kidney diseases, ESBL, MBL. (JPMA 66: 705; 2016)
Introduction
Chronic kidney disease (CKD) is a condition in which kidneys become impaired and they cannot perform efficiently their vital function, i.e.to remove waste from blood. As they get impaired, the body starts accumulating waste which leads to other health problems. It is estimated that almost 10% (<20 million) adult population in the United States suffers from CKD. The propensity to acquire renal dysfunction increases with age. CKD may lead to kidney failure, a condition in which kidneys stop working and the waste can no longer be removed from blood. Kidney failure is also known as end-stage renal disease (ESRD) or Stage 5 CKD.1 During this stage, other health problems such as oedema, pulmonary oedema, pericarditis and hyperkalaemia may occur. Hyperkalaemia so caused may prove to be fatal. Moreover, chances of a fracture are significantly increased, anaemia may be instigated, immunity gets compromised, and hence the overall quality of life gets worse. To deal with ESRD, dialysis or a kidney transplant is required to survive.2
Infectious diseases have always remained a leading cause of death throughout the history of mankind, particularly in chronic disease patients. In the United States, infections are the second leading cause of death in ESRD patients, with bacterial septicaemia alone accounting for more than 75%. Particularly, catheter-related bacteraemia is always a major problem in haemodialysis (HD) patients.3,4 A study was conducted to compare the mortality caused by sepsis in patients with ESRD to the general population. Dialysis patients were found to be 100-300 times and renal transplant recipients (RTRs) 20 times more prone to death compared with the general population.4
As CKD is always concomitant with immune system deficiencies, patients undergoing dialysis become more vulnerable to a healthcare-associated infection (HAI) because of the frequent use of urinary catheters, needles and injections. Because this procedure is always carried out in a hospital setting, the probability of communicable diseases between patients and healthcare workers increases manifold. According to an analysis, one in every 25 in-patients has an infection related to hospital care at any given time.5
The detection of bacteraemia is vital for early and appropriate antimicrobial therapy. Despite advanced molecular techniques, automated blood culture is preferred. It is also preferred over conventional blood culture system because it produces results more rapidly and supports antimicrobial susceptibility testing which is not possible through molecular techniques.6
In HD patients it is a common observation that bacteraemia gets complicated with endocarditis, epidural abscess, purulent pericarditis, septic arthritis, septic pulmonary emboli, liver abscess and endophthalmia.7 Sepsis itself poses a threat to HD or CKD patients, but if it is caused by resistant pathogens the situation becomes even more gruesome.
Antibiotic resistance in common pathogens is the challenge of today\\\'s clinical practice. All those pathogens that are resistant to three or more antimicrobials are colloquially termed as multi-drug resistant (MDR). Similarly, the pathogens resistant to at least one antimicrobial in each antibiotic category are called extensively drug resistant (XDR) and those resistant to all antimicrobials are known as pan-drug resistant (PDR).8 The determination of prevalence of resistance among CKD and RTRs is essential to be assessed for appropriate therapy. MDR pathogens are posing a treatment threat and emerging as a major cause of morbidity and mortality worldwide. Unfortunately, proper surveillance and documentation of such pathogens are scarce in many countries, especially developing ones. The current study was planned to see the incidence of sepsis, their causative agents and the antimicrobial susceptibility of various isolates among CKD patients on dialysis and RTRs.
Materials and Methods
The cross-sectional study was carried out at Kidney Centre, Al-Sayyed Hospital, Rawalpindi, Pakistan, from June to December 2014, in collaboration with the Microbiology Department of COMSATS Institute of Information Technology, Islamabad. It comprised CKD patients and RTRs.
Every patient coming to the centre for treatment had to submit four samples for microbiological analysis i.e., urine, throat swab, nasal swabs and blood. For this study we collected only blood samples, which were as a routine submitted to microbiology lab before and after every transplant surgery of both the donor and recipient. Samples of only the recipients were included. Data of donors from the total number of samples was excluded.
Venous blood (5-8ml) was collected via a sterile syringe. The patients were mainly from intensive care unit (ICU) after renal transplant or on maintenance therapy. Skin was disinfected with 70% alcohol and 5ml venous blood was collected into Versa TREK REDOX 1® (aerobic) bottles.6 All bottles were incubated in Versa Trek blood culture system within two hours of receipt for 5 days. Once a signal was detected on the system, the time to detection (TTD) was recorded. Only those bottles giving a positive signal were further investigated. This was followed by inoculation on blood agar, chocolate agar plate and MacConkey agar. These were incubated aerobically at 35°C for 18-24 hours and observed for growth. Blood culture bottles were regarded as negative after five days of incubation with no positive signal being emitted.
Microbial identification of positive growth was done through gram staining, catalase, oxidase test and by analytical profile index kit (API 20 E). All the microbes were identified and regarded as potential pathogens.
Antibiotic susceptibility testing was done by Kirby-Bauer disc diffusion method. Twenty-four-hour-old suspensions of the pathogens were compared with 0.5 McFarland turbidity standard and microbial lawn was prepared after dipping the sterile swab in microbial suspension. Excess suspension was removed by pressing the swab against container walls and Mueller Hinton plates were inoculated with test organisms four-dimensionally. Antibiotic discs (Oxoid, England) were selected using Clinical and Laboratory Standard Institute (CLSI) guidelines depending upon the type of pathogen. All the plates containing antibiotic discs were incubated overnight at 37°C. Zones of inhibition were then measured the next day and again interpreted according to CLSI guidelines.9
Extended spectrum beta lactamases (ESBL) was detected by double disc diffusion test. An amoxyclav (amoxicillin/clavulonic acid 30/10 µg) disc was placed in the middle of petriplate and third-generation cephalosporin discs were placed 20-30mm away from the central disc. An extension in the zone of inhibition, so-called keyhole effect, was considered positive for ESBL production (Figure)
. Carbapenem resistance was measured by susceptibility profile of imipenem and meropenem discs, i.e. zone less than 25mm was considered resistant. Likewise, Methicillin Resistant Staphylococcus aureus (MRSA) was detected phenotypically by resistance to cefoxitin disc (30µg). All those S.aureus giving a zone of inhibition less than 22mm were considered MRSA. Microsoft Excel 2010 was used for data analysis.
Results
Of the 1400 blood samples screened, only 46 samples (3.3%) had clinically important pathogens indicating septicaemia. Of these 46 microbes, 17 samples (37%) were Extended Spectrum beta-lactamase (ESBL) positive pathogens (Table-1)
. It was marked by increase in zone of inhibition between Augmentin (AMC) and cephalosporin discs (Figure). Moreover, ESBL production in E. coli was detected to be 81%, whereas 100% amongst Klebsiella pneumoniae. Carbapenem resistance was observed to be 15% (Table-2)
. Prevalence of resistance of pathogens to various antibiotic discs is described in Table-2.
Furthermore, it is evident from table 1 that 7 samples (i.e., 15%) yielded growth of Staphylococcus aureus and were susceptible to many antibiotics; however, only one of them was Methicillin-resistant Staphylococcus aureus (MRSA) positive and it represents 2% of total sample population. Acinetobacter baumannii was detected in 2 samples (4%) and Pseudomonas aeruginosa in 5 samples (11%).
Discussion
Bacterial infections represent a common and serious health problem for patients with ESRD and those who undergo maintenance HD.10 All these patients illustrate the challenges inherent to this problem.7 United States Renal Data System (USRDS) also considers septicaemia a leading cause of death among these patients. Indeed, in immune-compromised patients neutrophil dysfunction may occur, disturbing the whole process of infection control. Nonetheless, we found the prevalence of septicaemia very low among CKD patients, i.e. only 3.2%. It might be because, firstly, we screened all the patients who were admitted and came to the outpatient department (OPD) with or without symptoms of sepsis; secondly, the study included repetitive samples as well and thirdly, most of the patients were already taking antibiotics at the time of sampling.
In addition to the risk of being immune-compromised, HD patients are considered more susceptible to nosocomial infections, particularly ESBL-positive microbes. Although HD has been recognised as a risk factor for the acquisition of ESBL infections, there is limited information regarding the ESBL-bacteraemia in HD patients.11 ESBL-producing E. coli and Klebsiella species continue to increase in frequency and severity.12 The study indicated the prevalence of ESBL among CKD patients at36.9%. Unfortunately more than 80% of the E.coli and 100% of the K.pneumoniae samples were found to be positive for ESBL production. Our results corresponded with a previous study where the prevalence of ESBL in Pakistani samples was observed to be more than 80%.13 However, it varies from region to region. According to another study, prevalence of ESBL-producing E.coli in faecal samples was found to be 8.3%.14 Prevalence of ESBL-positive K.pneumoniae was recorded to be 27.2% amongst K.pneumoniae bacteraemia compared to 100% in our study. All ESBL-positive microbes were resistant to ampicillin, augmentin, doxycycline, cefoperazone, cefotaxime, ceftazidime, cefixime, ceftriaxone and cefipime. All were found to be susceptible to colistin (Table-2).
The emergence of carbapenem-resistant enterobacteriaceae (CRE) has invalidated almost all the available therapies. It is indicating an alarming situation that once easily treatable infections may become untreatable or very difficult to be managed. K.pneumoniae carbapenemase (KPC) and New Delhi Metallo-beta-lactamase (NDM) are the recently discovered types of CRE. KPC and NDM are the enzymes that break down carbapenems and make them ineffective. Emergence of Metallo Beta Lactamase (MBL)-mediated resistance is a serious concern. Carbapenem was considered to be highly effective for ESBL-positive enterobacteria. However, the present occurrence and dissemination of carbapenem resistance is a challenging situation that warrants effective management.15 Though the confirmation of MBL is done via molecular techniques, we did phenotypic detection by using Imipenem and Meropenem discs. Our results indicated its existence in 15% isolates. Another study reported 36% prevalence of ESBL producer among urinary isolates and they were all sensitive to carbapenems.16 Four of our ESBL-positive samples displayed carbapenem resistance as well.
Overuse of antibiotics is the main reason for development of antibiotic resistance. Surveillance is an absolute necessity to get a good control over these resistant superbugs. It is also important to detect ESBL production and to report it properly even when cephalosporins are in the susceptible range and to report ESBL-producing organisms as resistant to aztreonam and all cephalosporins (except cephamycins) as they will be ineffective in-vivo.16 The frequency of MDR P.aeroginosa was reported to be 22.7% in a study17 compared to our results of11%. P. aeruginosa have developed resistance to polymyxins, aminoglycosides, quinolones and carbapenems. Our samples displayed high resistance in P. aeruginosa. Carbapenem resistance was 20% while colistin resistance was 40%.
Almost a decade back, resistance in gram-positive microbes was considered to be reaching a critical level. However, with the implementation of control policies and through the development of new medicines, it is considered to be under good control now. Methicillin-resistant Staphylococcus aureus (MRSA) is a very versatile and dangerous pathogen causing infections ranging from mild skin infections to life-threatening ones. More than 60% of all the S.aureus isolates in ICUs of US hospitals were MRSA. These infections kill19,000 hospitalised American patients annually, similar to the number of deaths due to acquired immunodeficiency syndrome (AIDS), tuberculosis, and viral hepatitis combined.18 However, we could get only one MRSA from our sample pool. Furthermore, all the gram-positive microbes were susceptible to linezolid, teicoplanin, tigecycline and vancomycin. Maximum resistance was served for penicillin where it accounted for 90%. Besides,50% samples were found to be resistant for quinolones.
Conclusion
Bacterial infections, particularly sepsis, is considered to be a big threat for ESRD patients who are on maintenance therapy or having had kidney transplants. There is a high prevalence of ESBL in E. coli and K. pneumoniae. MBL prevalence is also displaying an escalating trend. Thus, the situation is quite worrisome for gram-negative microbes with respect to current therapeutic options. However, gram-positive microbes are under good control and are susceptible to many available antibiotics.
Disclosure: The article or part of the article has not been published in any other journal.
Conflict of Interest: None.
Financial Support: None.
References
1. Grandfils N, Detournay B, Attali C, Joly D, Simon D, Vergès B, et al. Glucose lowering therapeutic strategies for type 2 diabetic patients with chronic kidney disease in primary care setting in france: a cross-sectional study. Int J Endocrinol. 2013;2013:640632.
2. Centers for Disease Control and Prevention. National diabetes statistics report: estimates of diabetes and its burden in the United States, 2014. Atlanta, GA: US Department of Health and Human Services.
3. Michael A. Dialysis catheter-related bacteremia: Treatment and prophylaxis. Am J Kidney Dis. 2004; 44:779-91.
4. Sarnak MJ, Jaber BL. Mortality caused by sepsis in patients with end-stage renal disease compared with the general population. Kidney Int. 2000; 58:1758-64.
5. Evans RP. MRSA Clone Wars: Defeating the Epidemic. J Bone Joint Surg Am. 2014; 96:e95.
6. Dreyer AW, Ismail NA, Nkosi D, Lindeque K, Matthews M, van Zyl DG, et al. Comparison of the VersaTREK blood culture system against the Bactec9240 system in patients with suspected bloodstream infections. Ann Clin Microbiol Antimicrob. 2011;10:4.
7. George MN, Juan CA.Infectious complications of the hemodialysis access. Kidney Int. 2001; 60:1-13.
8. Magiorakos AP, Srinivasan A, Carey RB, Carmeli Y, Falagas ME, Giske CG, et al. Multidrug?resistant, extensively drug?resistant and pandrug?resistant bacteria: an international expert proposal for interim standard definitions for acquired resistance. Clin Microbiol Infect. 2012; 18:268-81.
9. Clinical. Laboratory Standards Institute, performance standards for antimicrobial susceptibility testing: 21st informational supplement. CLSI document M100-S21. Wayne, PA:TheInstitute;.CLSI (2012).
10. Abbott KC, Napier MG, Agodoa LY. Hospitalizations for bacterial septicemia in patients with end stage renal disease due to diabetes on the renal transplant waiting list. J Nephrol. 2002; 15:248-54.
11. Chih-Chao Y, Chien-Hsing W, Chien-Te L, Han-Tsung L, Jin-Bor C, Chien-Hua C, et al. Nosocomial extended-spectrum beta-lactamase-producing Klebsiellapneumoniae bacteremia in hemodialysis patients and the implications for antibiotic therapy. Int J Infect Dis. 2014;28: 3-7.
12. Helen WB, George HT, John SB, John EE, David G, Louis BR,et al. Bad Bugs, No Drugs: No ESKAPE! An Update from the Infectious Diseases Society of America.Clin Infect Dis 2009; 48:1-12.
13. Nahid F, Khan AA, Rehman S, Zahra R. Prevalence of metallo-?-lactamase NDM-1-producing multi-drug resistant bacteria at two Pakistani hospitals and implications for public health. J Infect PublicHealth. 2013; 6:487-93.
14. Susana C, Rui P, Hajer R, João CD, Pedro P, Daniela JD, et al. High prevalence of ESBL-producing Escherichia coli isolates among hemodialysis patients in Portugal: appearance of ST410 with theblaCTX-M-14 gene. DiagnMicrobiol Infect Dis. 2012; 74:423-5.
15. Aggarwal R, Chaughary U, SikkaR.Detcetion of extended spectrum b-Lactamases production among uropathogens. J Lab Physicians. 2009; 1: 7-10.
16. Paterson DL, Ko WC, Von GA, Casellas JM, Mulazimoglu L, Klugman KP, et al. Outcome of cephalosporin treatment for serious infections due to apparently susceptible organisms producing extended-spectrum ?-lactamases: implications for the clinical microbiology laboratory. J ClinMicrobiol. 2001; 39:2206-12.
17. Gill MM, Usman J, Kaleem F, Hassan A, Khalid A, Anjum R, et al. Frequency and antibiogram of multi drug resistant pseudomonas aeroginosa. J Coll Physicians Surg Pak. 2011; 21:531-4.
18. Boucher HW, Corey GR.Epidemiology of Methicillin-Resistant Staphylococcus aureus.Clin Infect Dis. 2008;46 Suppl 5:S344-9.
Journal of the Pakistan Medical Association has agreed to receive and publish manuscripts in accordance with the principles of the following committees:




